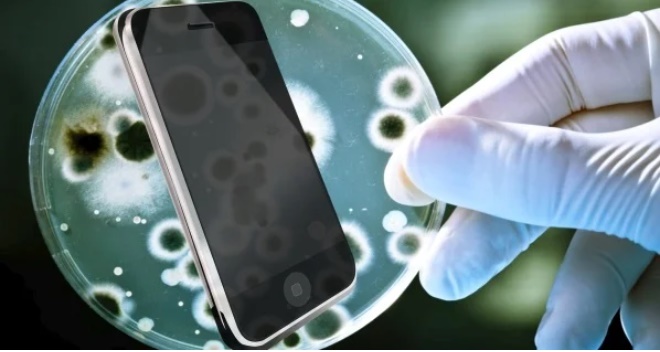

Bàn tay của chúng ta chạm vào rất nhiều thứ mỗi ngày, sau đó lại cầm lên điện thoại. Việc này tạo ra rất nhiều cơ hội để vi sinh vật di chuyển từ ngón tay đến điện thoại. Một nghiên cứu cách đây không lâu đã chỉ ra rằng điện thoại có hơn 17.000 vi khuẩn sống trên đó. Thậm chí các nhà khoa học còn nhận định rằng điện thoại di động mang nhiều vi khuẩn gấp 10 lần so với hầu hết các bồn cầu trong nhà vệ sinh.
Muốn loại bỏ được vi khuẩn sống trên điện thoại, bạn cần vệ sinh theo các cách dưới đây.
Sử dụng vải mềm hoặc vải dệt bằng sợi microfiber
Đặc tính của các loại vải dệt bằng sợ microfiber là mềm, mịn, bám bụi tốt. Dùng chúng để lau vết bẩn sẽ không làm ảnh hưởng đến màn hình.
Bạn làm ẩm khăn rồi lau nhẹ màn hình từ trên xuống theo chiều kim đồng hồ.
Sử dụng bông ngoáy tai
Với những vị trí khó làm sạch như khe, cổng sạc hay lỗ cắm tai nghe bạn có thể dùng bông ngoáy tai để kì cọ mạnh.
Đầu tiên bạn làm ẩm bông ngoáy tai sau đó chà lên vết bẩn. Bông ngoáy tai làm bằng sợi microfiber cũng có hiệu quả làm sạch tương tự.
Sử dụng giấm ăn
Giấm ăn có tính axit nên có khả năng làm sạch những vết bẩn cứng đầu trên màn hình cảm ứng.
Bạn pha giấm trắng và nước với tỉ lệ 50:50. Thấm ẩm khăn mềm rồi lau nhẹ nhàng lên màn hình điện thoại. Sau cùng lau khô lại bằng khăn sạch. Khi sử dụng giấm bạn chỉ nên dùng một lượng nhỏ.
Sử dụng cồn isopropyl
Các nhà sản xuất smartphone không khuyến nghị sử dụng chất tẩy rửa có sử dụng isopropyl nhưng vì hiệu quả tẩy rửa cao nên trong một vài trường hợp bạn vẫn có thể tham khảo.
- Đầu tiên pha loãng cồn isopropyl với nước theo công thức 60% nước và 40% cồn isopropyl.
- Cho dung dịch vào chai xịt rồi xịt làm ướt một chún khăn mềm. Tuyệt đối không đổ trực tiếp dung dịch lên thiết bị.
- Dùng khăn lau nhẹ nhàng lên màn hình. Không nên ấn mạnh vì có thể làm hỏng điện thoại.
- Đợi một lúc cho màn hình khô thì dùng một miếng vải mềm khác lau khô lại điện thoại.
Theo Khoevadep
